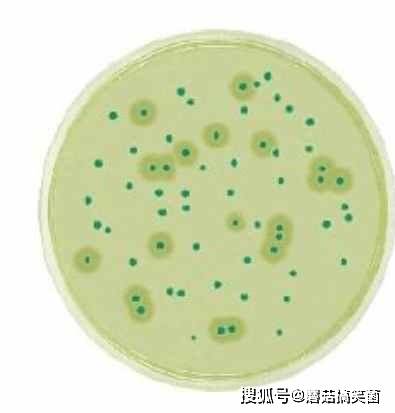
什么是动物源性蛋白 f658a49564c24113bc87db5137b3a564.jpeg

什么是动物源性蛋白_什么是动物源性蛋白
*** 次数:1999998 已用完,请联系开发者***

2025年中国动物源胶原蛋白行业市场规模及行业发展趋势分析动物源胶原蛋白是构成动物体内结缔组织的主要成分,具有良好的生物相容性和保湿性。因其出色的营养价值和功能性,动物源胶原蛋白广泛应... 主要对动物的相应部位进行去脂、切片、清洗、消毒、粉碎、反应、过滤、纯化等步骤获得胶原原液;下游则是动物源胶原蛋白的应用领域,包...

2025年中国动物源胶原蛋白行业生产工艺及下游应用分析动物源胶原蛋白是构成动物体内结缔组织的主要成分,具有良好的生物相容性和保湿性。因其出色的营养价值和功能性,动物源胶原蛋白广泛应... 主要对动物的相应部位进行去脂、切片、清洗、消毒、粉碎、反应、过滤、纯化等步骤获得胶原原液;下游则是动物源胶原蛋白的应用领域,包...

●^● 吃桃胶可以美容养颜?口服可以补充人体所需胶原蛋白,美容养颜。但事实上,桃胶的主要成分为多糖类物质,还含有少量蛋白质、多酚等。其本质是植物性膳食纤维,而非胶原蛋白。胶原蛋白是动物结缔组织中的蛋白质,植物中不存在此类成分,因此桃胶无法直接补充人体所需的胶原蛋白。 此外,“口服胶原蛋白...
![]()
ˋωˊ 动物实验显示:一种关键蛋白可能是调控大脑衰老的“主开关”大脑衰老背后隐藏着一种名为FTL1的关键蛋白。实验显示,过量FTL1蛋白会导致小鼠记忆力衰退、大脑神经连接减弱以及细胞反应迟钝。一旦阻断这种蛋白,老年小鼠就能恢复年轻时期的大脑功能与敏锐记忆力。这一突破性发现表明,FTL1很可能是调控大脑衰老的一个“主开关&r...
≥﹏≤ 黑坑鲤鱼饵中动物蛋白含量有多重要?动物蛋白能够促进鲤鱼肠道的健康发育,提高肠道的吸收效率。研究表明,适量的动物蛋白可以改善鲤鱼肠道的组织结构,增强其消化和吸收功能。动物蛋白富含鱼类所需的必需氨基酸,如赖氨酸和蛋氨酸,这些氨基酸在植物性蛋白中往往含量不足。 黑坑鲤鱼饵中动物蛋白含量的重要性 三、...

黑坑鲤鱼饵:动物蛋白含量为何如此重要?动物蛋白能够促进鲤鱼肠道的健康发育,提高肠道的吸收效率。研究表明,适量的动物蛋白可以改善鲤鱼肠道的组织结构,增强其消化和吸收功能。动物蛋白富含鱼类所需的必需氨基酸,如赖氨酸和蛋氨酸,这些氨基酸在植物性蛋白中往往含量不足。 黑坑鲤鱼饵中动物蛋白含量的重要性 三、...
╯△╰
免疫力总“开小差”?这些食物是“秘密武器”,帮你支棱起来!优质动物性蛋白 瘦肉、鱼类、蛋类和奶制品是优质动物性蛋白的优质来源。牛肉富含铁和蛋白质,有助于免疫细胞生成;三文鱼、鳕鱼等深海鱼,不仅蛋白质丰富,还含Omega-3脂肪酸,能调节免疫系统;鸡蛋营养全面,蛋黄中的卵磷脂和维生素对免疫细胞功能意义重大;牛奶和酸奶富含钙与优...

2025年中国胶原蛋白食品行业市场规模、重点企业及行业发展趋势胶原蛋白食品,是指以胶原蛋白为主要成分或添加了胶原蛋白成分,旨在为人体补充胶原蛋白,以期望对皮肤、骨骼、关节等身体组织发挥积极作用的食品。胶原蛋白是一种生物性高分子物质,是动物结缔组织中的主要成分,它具有很强的伸张能力,是韧带和肌腱的主要成分,在人体中起着支撑...

2025年全球及中国胶原蛋白食品行业发展背景、产品分类及市场规模胶原蛋白食品,是指以胶原蛋白为主要成分或添加了胶原蛋白成分,旨在为人体补充胶原蛋白,以期望对皮肤、骨骼、关节等身体组织发挥积极作用的食品。胶原蛋白是一种生物性高分子物质,是动物结缔组织中的主要成分,它具有很强的伸张能力,是韧带和肌腱的主要成分,在人体中起着支撑...
ˋ^ˊ 
+﹏+ 肾病患者能吃蛋白食物吗?医生:能,但要警惕3点尤其是动物性蛋白。其实,蛋白质并非肾病患者的“天敌”,而是他们生活中的必要营养成分。 医生们明确表示,肾病患者是可以吃蛋白的,但有三... 您有什么看法?欢迎评论区一起讨论![玫瑰][玫瑰][玫瑰] 参考资料 [1]李娜.不同蛋白饮食对肾病综合征患者的影响研究[J].中国冶金工业医学杂志,...
≥^≤ 
立马加速器部分文章、数据、图片来自互联网,一切版权均归源网站或源作者所有。
如果侵犯了你的权益请来信告知删除。邮箱:xxxxxxx@qq.com